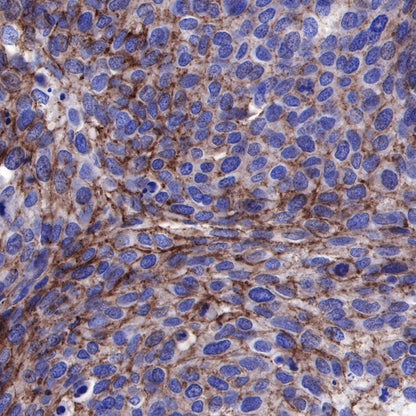
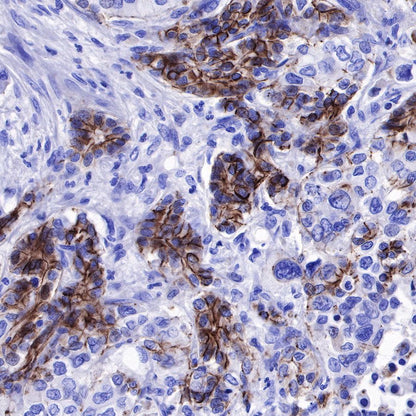

Product Specification
| Host |
Rabbit |
| Antigen |
NECTIN-4 |
| Synonyms |
LNIR, PRR4, PVRL4 |
| Immunogen |
Recombinant Protein |
| Location |
Cell membrane |
| Accession |
Q96NY8 |
| Clone Number |
SDT-277-229 |
| Antibody Type |
Recombinant mAb |
| Application |
WB, IHC-P |
| Reactivity |
Hu |
| Purification |
Protein A |
| Concentration |
0.5 mg/ml |
| Tag |
N/A |
| Physical Appearance |
Liquid |
| Storage Buffer |
PBS, 40% Glycerol, 0.05% BSA, 0.03% Proclin 300 |
| Stability & Storage |
12 months from date of receipt / reconstitution, -20 °C as supplied |
Dilution
| application |
dilution |
species |
| WB |
1:1000 |
|
| IHC-P |
1:500 |
|
Background
The Nectin cell adhesion molecule (Nectin) family members are Ca2+‑independent immunoglobulin‑like cellular adhesion molecules (including Nectins 1‑4), involved in cell adhesion via homophilic/heterophilic interplay. In addition, the Nectin family plays a significant role in enhancing cellular viability and movement ability. In contrast to enrichment of Nectins 1‑3 in normal tissues, Nectin‑4 is particularly overexpressed in a number of tumor types, including breast, lung, urothelial, colorectal, pancreatic and ovarian cancer. Moreover, the upregulation of Nectin‑4 is an independent biomarker for overall survival in numerous cancer types [PMID: 34664682].